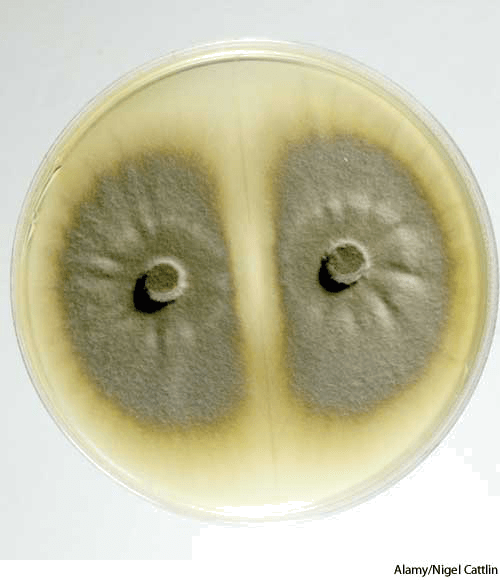

| 释义 |
cul·ture AHD[kŭlʹchər] D.J.[ˈkʌltʃə]K.K.[ˈkʌltʃɚ]n.(名词) cultureculture of rice blast fungus, Pyricularia grisea, growing in a petri dish- The totality of socially transmitted behavior patterns, arts, beliefs, institutions, and all other products of human work and thought.人类文化:通过社会传导的行为方式、艺术、信仰、风俗以及人类工作和思想的所有其它产物的整体
- These patterns, traits, and products considered as the expression of a particular period, class, community, or population:特种文化:被视为表现某一特定阶段、阶级、社会或种族的这些方式、特点和产物:Edwardian culture; Japanese culture; the culture of poverty.爱德华时代的文化;日本文化;贫困文化
- These patterns, traits, and products considered with respect to a particular category, such as a field, subject, or mode of expression:类别文化:被视为关于某一特定范畴,如某一领域、主题或表达方式的这些方式、特点或产物:religious culture in the Middle Ages; musical culture; oral culture.中世纪时期的宗教文化;音乐文化;口头文化
- Intellectual and artistic activity, and the works produced by it.文艺作品,文艺活动:智力和艺术活动以及由此产生的作品
- Development of the intellect through training or education.教养:通过训练或教育而实现的智力发展
- Enlightenment resulting from such training or education.陶冶,启发:由这类训练或教育而得到的启迪
- A high degree of taste and refinement formed by aesthetic and intellectual training.修养,教养:通过美学和智力训练而形成的高品味和文雅
- Special training and development:培训:特殊的训练和发展:voice culture for singers and actors.为歌手和演员准备的声音练习
- The cultivation of soil; tillage.土地的耕作;耕种
- The breeding of animals or growing of plants, especially to produce improved stock.养殖:对动物的饲养或植物的种植,尤指为了产生改良品种
- Biology 【生物学】
- The growing of microorganisms, tissue cells, or other living matter in a specially prepared nutrient medium.培养:在经过特殊准备的营养培养基中的微生物、组织细胞或其它生物的培养
- Such a growth or colony, as of bacteria.培养菌:该种生长物或群落,如培养菌
v.tr.(及物动词)cul.tured, cul.tur.ing, cul.tures - To cultivate.栽培
- To grow (microorganisms or other living matter) in a specially prepared nutrient medium.培养:在特殊制备的营养培养基中培养(微生物或其它生物)
- To use (a substance) as a medium for culture:用作培养基:用(某一物质)作营养培养基:culture milk.用牛奶作培养基
- Middle English [cultivation] 中古英语 [培育]
- from Old French 源自 古法语
- from Latin cultūra 源自 拉丁语 cultūra
- from cultus [past participle of] colere * see cultivate 源自 cultus colere的过去分词 * 参见 cultivate
culture, cultivation, breeding, refinement, taste- These nouns denote a personal quality resulting from the development of intellect, manners, and aesthetic appreciation.这些名词的意思是由智力、举止以及美学欣赏的发展而形成的个人素质。
- Culture implies enlightenment attained through close association with and appreciation of the highest level of civilization: Culture 指的是通过与最高层次的文明接触并欣赏而获得的启发: "Culture is then properly described not as having its origin in curiosity, but as having its origin in the love of perfection" (Matthew Arnold). “由此修养被恰当地描述为源于对完美的热爱,而不是出于好奇心” (马修·阿诺德)。
- Cultivation suggests the process of self-improvement or self-development through which culture is acquired: Cultivation 指的是修养得以获取的自我改进或自我发展过程: The books and paintings in her library reflect her considerable cultivation.她的图书馆内的书和画反映了她有相当程度的修养。
- Breeding is revealed especially in good manners, poise, and sensitivity to the feelings of others: Breeding 尤指在优雅的举止、姿态以及对他人感觉的敏感中表现出来的: "The test of a man's or woman's breeding is how they behave in a quarrel" (George Bernard Shaw). “对某一男人或女人教养的考验是他们在争吵中如何表现” (乔治·萧伯纳)。
- Refinement stresses aversion to coarseness and implies a delicacy of feeling associated with fastidiousness: Refinement 强调的是对粗鲁的厌恶并且有与挑剔相关的感觉敏感之意: "to seek elegance rather than luxury,and refinement rather than fashion" (William Henry Channing). “寻求典雅而不是奢侈,寻求高雅而不是时尚” (威廉·亨利·查宁)。
- Taste is the capacity for recognizing and appreciating what is fitting, proper, or aesthetically superior: Taste 指的是辨别和鉴定合适的、适宜的、美学方面优良东西的能力: "These questions of taste, of feeling, of inheritance, need no settlement.Every one carries his own inch-rule of taste" (Henry Adams). “这些关于品味、感觉、遗传的问题,无需得到解决。每个人都有各自衡量审美力的标准” (亨利·亚当斯)
|